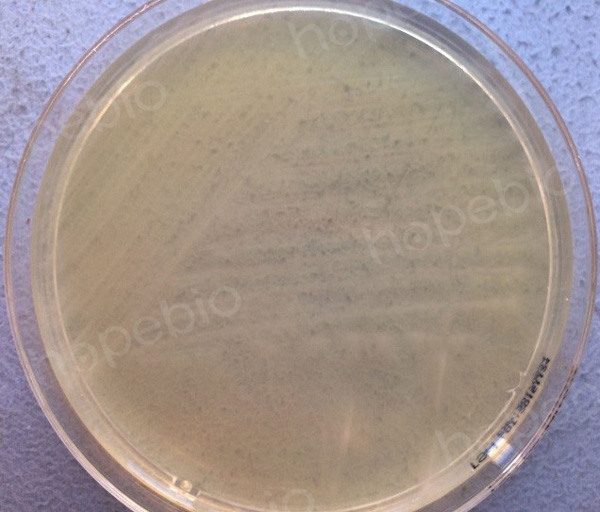

海博微信公众号
海博天猫旗舰店




一、试验原理:
丁酸梭菌又叫酪酸梭菌,是一种严格厌氧的革兰氏阳性芽孢杆菌,菌体呈杆状或稍有弯曲,周身鞭毛,能运动。酪酸梭菌是人的正常肠道菌群之一,有氧条件不生长,革兰氏染色为阳性,能够发酵乳糖、麦芽糖、棉籽糖、甘露醇等碳水化合物产酸,不发酵山梨醇,硝酸盐还原试验为阴性。
二、试验步骤及结果
1、将1小包丁酸梭菌活菌散溶解于含9mL无菌生理盐水的试管内,取1mL菌液加入至厌氧疱肉培养基内,置于35℃恒温箱内培养。
图1疱肉培养基
培养24h后,疱肉培养基浑浊,并产生大量气泡。
2.用接种环挑取疱肉培养基菌液划线接种于TSA平板,放入厌氧袋内,并放入厌氧产气包,置于35℃恒温箱内进行厌氧培养,另划线接种TSA平板,置于有氧条件下35℃恒温箱进行培养。
图2 TSA平板上的菌落形态
培养24h后,有氧条件培养下的TSA平板上无任何菌落生长,厌氧条件培养下的TSA平板细菌生长良好,菌落为白色且形状不规则,沿接种线向周围扩散生长,表明该菌生长条件为严格厌氧,且具有较强动力。
3.从纯培养后的TSA平板上挑取菌落进行革兰氏染色,在油镜下观察菌体形态。

图3 油镜下的菌落革兰氏染色
该菌的革兰氏染色为阳性,显微镜下菌体为紫色杆状,两端钝圆,部分菌体稍有弯曲。
4.挑取TSA上纯培养的单菌落至9mL无菌生理盐水试管内,分别接种于乳糖、麦芽糖、棉籽糖、甘露醇、山梨醇和硝酸盐还原生化管,置于35℃恒温培养箱内厌氧培养。

图4 生化反应鉴定
培养24h后,该菌生化反应结果为乳糖阳性(变黄)、麦芽糖阳性(变黄)、棉籽糖阳性(变黄)、甘露醇阳性(变黄)、山梨醇阴性(颜色不变)、硝酸盐还原阴性(加试剂不变色,加锌粒后变红),该结果符合丁酸梭菌的典型生化反应特征。
三、注意事项
本培养基仅为细菌鉴定的一部分,需做其他补充试验。
注:本文属海博生物原创,未经允许不得转载。
上一篇:微生物试验用菌的挑选及注意事项
